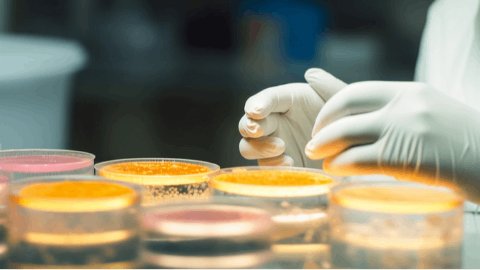

预约演示
更新于:2025-05-07
AM-1939
更新于:2025-05-07
概要
基本信息
在研机构- |
权益机构- |
最高研发阶段无进展药物发现 |
首次获批日期- |
最高研发阶段(中国)- |
特殊审评- |
关联
100 项与 AM-1939 相关的临床结果
登录后查看更多信息
100 项与 AM-1939 相关的转化医学
登录后查看更多信息
100 项与 AM-1939 相关的专利(医药)
登录后查看更多信息
33
项与 AM-1939 相关的文献(医药)2018-08-01·Microbial Genomics
Genomic surveillance of Neisseria gonorrhoeae to investigate the distribution and evolution of antimicrobial-resistance determinants and lineages
Article
作者: Ohya, Hitomi ; Deguchi, Takashi ; Nakayama, Shu-ichi ; Kawahata, Takuya ; Ohnishi, Makoto ; Shimuta, Ken ; Yahara, Koji ; Watanabe, Yuko ; Yasuda, Mitsuru ; Morita, Masatomo ; Lee, Ken-ichi ; Didelot, Xavier ; Kuroki, Toshiro
2016-02-01·Experimental Parasitology4区 · 医学
Evaluation of in vitro inhibitory effect of enoxacin on Babesia and Theileria parasites
4区 · 医学
Article
作者: Ahmed Elsify ; Mosaab A. Omar ; Mohamed Abdo Rizk ; Shimaa Abd El-Salam El-Sayed ; Ikuo Igarashi ; Akram Salama ; Mohammad Saleh Al-Aboody ; Mahmoud AbouLaila
2015-05-01·Journal of the College of Physicians and Surgeons--Pakistan : JCPSP4区 · 医学
Extensively and pre-extensively drug resistant tuberculosis in clinical isolates of multi-drug resistant tuberculosis using classical second line drugs (levofloxacin and amikacin).
4区 · 医学
Article
作者: Khan, Farooq Ahmad ; Mirza, Irfan Ali ; Khan, Khursheed Ali ; Ghafoor, Tahir ; Fayyaz, Muhammad ; Satti, Luqman
3
项与 AM-1939 相关的新闻(医药)2025-04-11
Our analysis of February data reveals key trends in global clinical-stage biopharmaceutical financing. For contextual understanding, we recommend beginning with the following article.
Highlights of February 2025: Biopharmaceutical Clinical-Stage Drug Investment, Financing, and Collaboration Deals (1)
11. Kyorin and Cyrano Therapeutics Enter into an Option Agreement for the Development and Commercialization of CYR-064 in Japan
On February 14, 2025, Kyorin Pharmaceutical Co., Ltd. and Cyrano Therapeutics, Inc. announced the signing of an option agreement for the novel drug CYR-064, which is designed to treat hyposmia following viral infections. Under the terms of this agreement, Kyorin has obtained the rights to develop and commercialize CYR-064 in Japan and will pay an option fee. Once the option is exercised and a licensing agreement is signed, Kyorin will also provide Cyrano with an upfront payment, milestone payments based on development and commercialization progress, and royalties calculated as a percentage of net sales after the product is launched.
CYR-064 is a patented intranasal formulation of theophylline, a broad-spectrum phosphodiesterase inhibitor (PDEi), which increases intracellular cAMP levels by inhibiting cAMP degradation, thereby enhancing the excitability of olfactory neurons. This provides a potential therapeutic pathway for treating hyposmia following viral infections and other olfactory disorders. Currently, CYR-064 is undergoing a Phase II clinical trial in the United States, with trial data expected in the second half of 2025.
Guided by its long-term vision "Vision 110," Kyorin Pharmaceutical is committed to creating high-value new drugs that meet medical needs. By actively leveraging open innovation strategies, Kyorin plans to continuously launch new drugs. This collaboration with Cyrano is part of its strategic implementation, aiming to accelerate the development and commercialization of CYR-064 in the Japanese market to address unmet medical needs.
For the fiscal year ending in March 2025, this agreement is not expected to have a significant impact on Kyorin's business performance. However, with further development of CYR-064 and its potential market success, Kyorin anticipates positive financial returns in the coming years. Meanwhile, this collaboration also opens up new prospects for finding effective treatments for hyposmia following viral infections on a global scale.
12. Royalty Pharma Invests $250 Million to Support Biogen's Lupus Drug Litifilimab Development
Royalty Pharma has entered into a $250 million agreement with Biogen to support the development of Biogen's late-stage experimental lupus drug litifilimab. Under the terms of the agreement, Biogen will receive this amount over the next six quarters. In return, if the drug achieves specific regulatory milestones, Royalty Pharma will receive undisclosed milestone payments and a mid-single-digit royalty on global sales. This transaction not only enhances Royalty Pharma's product portfolio but also brings more opportunities for potential revenue.
Litifilimab is an anti-BDCA2 antibody currently in Phase III trials for systemic lupus erythematosus (SLE) and cutaneous lupus erythematosus (CLE). The drug has demonstrated significant reduction in skin disease activity in the Phase II LILAC study, showing effective relief of skin symptoms in CLE patients compared to the placebo group at the primary endpoint. If approved by 2030, litifilimab is projected to achieve up to $750 million in global sales. This potential allows Biogen to use the funds to further advance its development process.
Currently, the SLE market is dominated by generic drugs, with only a few targeted biologics approved by the U.S. Food and Drug Administration (FDA) in the past fifty years, such as GSK's Benlysta (belimumab) and AstraZeneca's Saphnelo (anifrolumab). In contrast, the CLE market is even more innovation-starved, with this form of lupus primarily affecting the skin, causing inflammation, rashes, and lesions. The successful development of litifilimab could change this status quo and provide new treatment options for patients.
13. Tivic Health Acquires Statera Biopharma's TLR5 Agonist Entolimod™ to Expand Its Therapeutic Pipeline
Tivic Health Systems, Inc. has announced the acquisition of global exclusive rights to the late-stage Toll-like receptor 5 (TLR5) agonist Entolimod™ from Statera Biopharma for the treatment of acute radiation syndrome (ARS). In addition, Tivic has obtained exclusive options for five additional indications and clinical uses of Entolimod and its derivative Entalasta™. This extensive licensing agreement transforms Tivic into a diversified therapeutic company with complementary bioelectronic and biologic candidates in its clinical pipeline.
As the lead candidate in the licensed portfolio, Entolimod is a TLR5 agonist specifically designed for the treatment of ARS. According to data from market research firm CoherentMI, the global ARS market was valued at $5.2 billion in 2024 and is projected to grow at a compound annual growth rate of 5% from 2024 to 2031. Entolimod and its immune-optimized derivative Entalasta have undergone over forty animal and human trials and received approximately $140 million in investment. The FDA has granted Entolimod Fast Track and Orphan Drug designations for the prevention or treatment of ARS and to prevent death following a potentially lethal dose of total-body ionizing radiation after a radiological disaster.
Animal studies for ARS have shown that a single dose of Entolimod administered 25 hours after exposure to a lethal level of radiation can triple survival rates. The drug is effective without additional supportive care, demonstrating gastrointestinal protective properties and no dose-limiting toxicity even at the highest doses. Other studies have also shown its potential in applications such as immunosenescence, lymphocyte exhaustion, neutropenia, vaccine enhancement, and chronic radiation syndrome.
Under the agreement, Tivic will initially pay Statera $1.2 million in equity consideration and $300,000 in cash for the use of Entolimod in treating ARS. Tivic has the option to add one or more indications and expand its licensing scope to Entolimod's derivative Entalasta by exercising the exclusive options granted in the agreement. Future potential payments will be royalty and milestone-driven, ensuring alignment with the clinical and commercial success of Entolimod and subsequent Entalasta. The agreement structure allows Tivic to strategically manage its investment while maximizing shareholder returns.
To establish Tivic's biopharmaceutical capabilities and advance the product candidates toward commercialization, some members of Statera's team will join Tivic. The transaction also includes exclusive rights and options to over sixty patents and pending patents, related proprietary technology, and ownership of previously manufactured and tested materials. Craft Capital Management LLC served as the sole investment banking firm in this deal. With these resources integrated, Tivic is steadily moving toward becoming a leading biotherapeutic company.
14. Oramed Pharmaceuticals Announces Formation of OraTech Pharmaceuticals to Accelerate Development and Commercialization of Oral Insulin
Oramed Pharmaceuticals Inc., a clinical-stage pharmaceutical company focused on the development of oral drug delivery platforms, recently announced that it will transfer its proprietary Protein Oral Delivery (POD™) technology to a new joint venture, OraTech Pharmaceuticals Inc., through a definitive agreement. This move is aimed at accelerating the development and commercialization of Oramed's oral insulin ORMD-0801 and other innovative oral drug delivery technologies based on the POD™ platform.
In this transaction, Oramed will transfer its proprietary oral insulin and POD™ technology, along with other pipeline assets, to OraTech. Oramed shareholders will receive a majority stake in the new entity, allowing them to directly participate in its future success. Additionally, under the terms of the agreement, Oramed and HTIT will jointly invest $75 million, with Oramed contributing $15 million and HTIT contributing $60 million. This funding will provide OraTech with the necessary resources to advance product development, commercialization, and clinical progress.
OraTech will leverage HTIT's expertise in capsule manufacturing and cost-effective production capabilities to establish a robust, reliable, and scalable supply chain to support clinical trials and commercial efforts. HTIT will also provide a supply agreement for the oral insulin capsules. Furthermore, OraTech plans to relaunch the pivotal Phase III clinical trial in the United States and advance the registration of oral insulin in the U.S. and other countries. In China, OraTech will receive royalties from the sales of oral insulin, while HTIT will be responsible for submitting marketing authorization applications and preparing for commercialization.
15. AdvanCell and Eli Lilly Expand Collaboration to Advance Cancer Targeted Alpha Therapy
On February 10, 2025, AdvanCell announced that its strategic partnership with Eli Lilly and Company has been further expanded. This collaboration aims to research and develop innovative treatments for various types of cancer. The partnership not only recognizes AdvanCell's leadership in the field of Pb-212 targeted alpha therapy but also lays the foundation for a long-term collaboration between the two companies.
Under the new cooperation agreement, both parties will utilize AdvanCell's proprietary Pb-212 production technology and radiopharmaceutical development infrastructure, as well as Eli Lilly's drug candidates and extensive drug development experience, to jointly advance the development of more targeted alpha radiopharmaceutical therapies and accelerate their clinical progress. AdvanCell's technological advantages and its infrastructure established in Australia to expedite early clinical trials enable it to quickly move novel radiotherapeutic drugs containing Pb-212 from the discovery phase to clinical trials.
AdvanCell is currently conducting a Phase I/II trial for ADVC001, a potentially best-in-class targeted alpha therapy for metastatic prostate cancer. The trial aims to assess the safety and efficacy of the Pb-212-based radiopharmaceutical therapy. The core product ADVC001 is designed to bind to PSMA (a cell surface target highly expressed in prostate cancer) and has demonstrated potential best-in-class characteristics in preclinical studies. This collaboration is expected to accelerate the development of ADVC001, bringing new hope to patients with prostate cancer.
As the partnership between AdvanCell and Eli Lilly continues to deepen, both parties are committed to achieving new breakthroughs in cancer treatment. By integrating their respective strengths and technologies, the two companies will not only accelerate the clinical progress of existing projects but also potentially open up new therapeutic pathways. For cancer patients who do not respond well to traditional therapies, targeted alpha therapy offers a more precise and less side-effect-prone treatment option. In the future, with the emergence of more research results, it is expected that more patients will benefit from this innovative cancer treatment method.
16. OliX and Eli Lilly Reach Global Licensing Agreement to Develop New Therapies for MASH and Other Cardiometabolic Indications
On February 10, 2025, OliX Pharmaceuticals announced a global licensing agreement with Eli Lilly and Company. This cooperation aims to jointly develop and commercialize OliX's OLX75016, a Phase I candidate drug primarily targeting metabolic-associated fatty liver hepatitis (MASH) and other cardiometabolic indications. Under the terms of the agreement, OliX will receive an upfront payment from Eli Lilly to support the ongoing Phase I clinical trial in Australia.
OLX75016 originates from robust targets identified through genome-wide association studies (GWAS), a method that can identify genomic variations in large populations. In preclinical studies, OliX has demonstrated the efficacy of OLX75016 in treating MASH, liver fibrosis, and other cardiometabolic indications. Currently, OliX is developing OLX75016 as a novel therapy for MASH with liver fibrosis and other cardiometabolic conditions.
OliX Pharmaceuticals is a clinical-stage pharmaceutical company focused on developing treatments for various diseases using its proprietary RNAi technology. The company's core RNAi platform—Asymmetric siRNA (asiRNA)—is a unique gene-silencing technology based on RNA interference (RNAi) and is considered one of the most effective gene-silencing technologies currently available. Using this proprietary asiRNA technology, OliX has developed cell-penetrating asiRNA (cp-asiRNA), a therapeutic RNAi platform that effectively targets diseases such as proliferative scar formation, dry and wet age-related macular degeneration (AMD), and subretinal fibrosis.
In addition to cp-asiRNA, OliX has also developed another therapeutic RNAi platform, GalNAc-asiRNA, specifically for targeting various liver diseases. This collaboration with Eli Lilly not only advances the development of OLX75016 but also further solidifies OliX's position in the biopharmaceutical field, demonstrating its commitment to addressing unmet medical needs through innovative technologies. As research and development progresses, it is anticipated that more new therapies based on these advanced technologies will emerge, bringing hope to patients worldwide.
17. Kineta Restructures Portfolio Ahead of Merger with TuHURA
Ahead of its merger with TuHURA Biosciences, Kineta has made significant adjustments to its portfolio. To streamline its investments, Kineta decided to sell its collaboration deals with Genentech and Merck & Co. to an investment company and transferred its pain treatment candidate drug KCP506 to Pacira Pharmaceuticals, while also terminating its cooperation agreement with GigaGen. TuHURA purchased Kineta for $15 million, with $5 million allocated to secure the exclusivity agreement. This acquisition enabled TuHURA to acquire Kineta's Phase II checkpoint inhibitor.
In 2018, Genentech paid Kineta a $5 million upfront payment to obtain the rights to a small molecule modulator and set milestone payments of up to $96 million. The collaboration was expanded in 2020 to support the early development phase of a pain treatment candidate drug. On the other hand, Kineta inherited a collaboration with Merck from its merger with Yumanity Therapeutics, which obtained a preclinical drug candidate for amyotrophic lateral sclerosis (ALS) and frontotemporal dementia from Yumanity in 2020. In 2023, Kineta received a $5 million milestone payment from Merck, with up to $255 million still pending.
KCP506 is an α9α10 nicotinic acetylcholine receptor (nAChR) antagonist that Kineta is developing for the treatment of chronic neuropathic pain. Kineta initiated a Phase II trial for this drug. Subsequently, Kineta agreed to sell KCP506 to Pacira Pharmaceuticals for $450,000, marking the end of Kineta's further development of KCP506.
A subsidiary of HealthCare Royalty Partners, HCRX Investments Holdco, reached an agreement with Kineta covering Kineta's licensing deals with Genentech and Merck, as well as its role in an agreement with Fair Therapeutics related to cystic fibrosis. This move will help Kineta focus its resources on the development of other key projects.
Finally, Kineta decided to terminate its option and licensing agreement with GigaGen, which originally granted Kineta the rights to a CD27 drug program. By terminating this agreement, Kineta not only returned all rights to GigaGen but also waived its obligation to pay a $180,000 fee. This strategic retreat allows Kineta to concentrate more on the upcoming merger and the development of its core business.
18. Fosun Pharma and Dr. Reddy's Reach Licensing Agreement for HLX15 in Europe and the U.S.
On February 6, 2025, Fosun Pharma announced a licensing agreement with Dr. Reddy's Laboratories for HLX15, a biosimilar to daratumumab, an anti-CD38 monoclonal antibody under development. HLX15 is a recombinant human anti-CD38 monoclonal antibody injection intended for the treatment of multiple myeloma and other hematologic malignancies. Under the agreement, Dr. Reddy's will obtain exclusive commercialization rights to the drug in 43 countries and regions, including 42 European countries and the United States. The collaboration aims to expand the drug's market coverage and provide advanced biologics to more patients.
According to the terms of the agreement, Fosun Pharma will be responsible for the development, production, and commercial supply of HLX15 and may receive up to $131.6 million in funding from Dr. Reddy's, including a $33 million upfront payment and additional milestone payments. Additionally, Fosun Pharma will receive royalties based on annual net sales. This arrangement not only provides Fosun Pharma with the necessary cash flow to support its ongoing research and development but also enhances its competitiveness in the global market.
HLX15, as a biosimilar, primarily works by targeting and inhibiting the function of the CD38 protein to combat multiple myeloma. CD38 is a protein highly expressed on the surface of certain cancer cells, and monoclonal antibodies targeting it can effectively identify and destroy these cells while minimizing impact on normal tissues. Therefore, HLX15 is expected to become an important option for treating such diseases.
19. Relmada Therapeutics Acquires Potential Tourette Syndrome Therapy Sepranolone from Asarina Pharma AB
On February 6, 2025, Relmada Therapeutics announced the acquisition of Sepranolone from Asarina Pharma AB, a therapeutic asset for Tourette Syndrome (TS) and other compulsive-related disorders, ready to enter Phase IIb clinical trials. Sepranolone (isoallopregnanolone) is a first-in-class GABAA modulatory steroid antagonist (GAMSA) that selectively acts on the GABAA pathway, aiming to counteract the effects of allopregnanolone on TS and other compulsive disorders.
An open-label Phase IIa randomized study showed that Sepranolone has the potential to improve TS symptoms, as measured by changes in the Yale Global Tic Severity Scale (YGTSS). In the 12-week study, Sepranolone not only reduced the primary clinical endpoint of tic severity by 28% (p=0.051) compared to standard care alone but also achieved positive results in four key secondary endpoints, including a 69% improvement in quality of life, a 50% reduction in functional impairment, and a 44% reduction in premonitory urges. Additionally, the drug did not exhibit off-target central nervous system effects or systemic adverse effects, which is a significant advantage for central nervous system disorders requiring long-term use and potentially severe side effects.
Under the terms of the agreement, Relmada acquired global ownership of Sepranolone from Asarina Pharma AB for €3 million, completing the transaction through an asset purchase agreement. This acquisition reflects Relmada's mission to find solutions for refractory central nervous system diseases and its strategic goal of enhancing shareholder value by identifying and developing innovative compounds.
Relmada will continue to evaluate additional products and strategic opportunities and expects to update investors on the next steps for Sepranolone's development later in 2025. With further clinical data support, if Sepranolone successfully transitions to later-stage clinical trials and ultimately receives approval, it is expected to become one of the first-line treatments for Tourette Syndrome, bringing new hope to patients.
20. Acelyrin Terminates Izokibep Program, Affibody Regains Drug Development Rights
In 2021, Acelyrin acquired the license for izokibep with a $25 million upfront payment and committed to milestone payments of up to $280 million. Izokibep is an IL-17A inhibitor with a molecular weight only about one-eighth that of a typical antibody, exhibiting extremely high affinity for IL-17A and capable of specifically binding to both subunits of IL-17A as well as albumin in the serum. However, less than two years later, despite raising $540 million through an initial public offering to fund the late-stage trials of izokibep across multiple indications, Acelyrin ultimately decided to cease investment in the drug.
Izokibep achieved the primary endpoint in a Phase III clinical trial for the treatment of hidradenitis suppurativa (HS), demonstrating a 33% reduction in abscesses and inflammatory nodules by 75% or more in patients, compared to 21% in the placebo group. Despite these positive results, Acelyrin chose to discontinue investment in this indication. Additionally, after achieving success in psoriatic arthritis (PsA), Acelyrin also withdrew its investment, retaining only uveitis as the final active development area for izokibep. However, the Phase IIb/III trial in this area failed to meet its primary and secondary endpoints.
With Inmagene Biopharmaceuticals terminating the agreement covering Asian countries, including China and South Korea, the responsibility for izokibep will now fall entirely on Affibody in Sweden. Affibody's CEO, David Bejker, stated that he believes his company can better capitalize on the potential of izokibep than its former partner, particularly in the field of dermatology and for patients severely affected by hidradenitis suppurativa. This indicates Affibody's confidence in the potential of its product and its determination to regain control of the project.
21. Vanda Pharmaceuticals and AnaptysBio Reach Global Exclusive Licensing Agreement for IL-36R Antagonist Imsidolimab
On February 3, 2025, Vanda Pharmaceuticals and AnaptysBio announced a global exclusive licensing agreement for imsidolimab, an IL-36R antagonist monoclonal antibody. Imsidolimab has completed two pivotal global Phase III clinical trials for generalized pustular psoriasis (GPP) - GEMINI-1 and GEMINI-2, demonstrating good safety and efficacy. This drug balances the inflammatory response by inhibiting the function of the IL-36 receptor, which is particularly important for GPP patients caused by mutations in the IL36RN gene.
Under the terms of the agreement, Vanda will pay AnaptysBio a $10 million upfront payment and $5 million for existing drug supplies. Additionally, AnaptysBio will be eligible for up to $35 million in future regulatory approval and sales milestone payments, as well as a 10% royalty on global net sales. In this transaction, Vanda has obtained the global exclusive rights to develop, produce, and commercialize imsidolimab. These funds will support further research and development efforts to ensure that imsidolimab can reach the market as soon as possible.
In the Phase III clinical trial of GEMINI-1, 53% of patients receiving a 750 mg intravenous injection of imsidolimab achieved a GPP Physician's Global Assessment (GPPPGA) score of 0/1 (skin almost or completely clear) at week 4, compared to only 13% in the placebo group (p=0.0131). In the subsequent GEMINI-2 trial, all patients in the maintenance dose treatment group maintained a GPPPGA score of 0/1 without relapse, while 63% of patients in the placebo group experienced disease worsening. These results indicate that imsidolimab has significant efficacy for GPP.
Summary
The clinical-stage drug investment, financing, and collaboration transactions in February 2025 revealed several trends: First, capital continues to be optimistic about innovative drugs, especially those with breakthrough therapeutic potential, and is willing to invest substantial funds to support research and development. Second, antibody-drug conjugates (ADCs) have become one of the key areas of collaboration, demonstrating the global popularity of this technology platform. Lastly, Chinese pharmaceutical companies are not only seeking growth opportunities in the domestic market but also actively expanding into international markets, accelerating the global layout and commercialization of new drugs through licensing deals and other means. These dynamics indicate that, despite the many challenges facing the pharmaceutical industry, companies are actively exploring new development paths through capital injection and technological collaboration, aiming to gain a favorable position in global competition.
How to get the latest progress on drug deals?
If you would like to access the latest transaction event information, you can click on the 'Deal' module from the homepage of the Synapse database. Within the Deal module, you can search for global pharmaceutical transaction information using labels such as Drugs, Organization, Target, Drug Type, Deal Date.
Furthermore, you can obtain the original link to the transaction coverage by clicking on the "Deal Name."
In the analysis view, you can see the most active assignors, assignees, popular targets, and other dimensions of analysis, as well as the distribution of research and development statuses at the time of the transaction, to help you better understand the search results.
The Synapse database also supports the ability to view current transactions from the dimension of "drugs" (by selecting "drugs" from the "Adjust Dimension" dropdown menu above). Targeting transactions involving renowned pharmaceutical companies that are of interest to the industry, such as Merck, Roche, etc., Synapse has identified a group of "leading companies" through drugs that have achieved global sales exceeding 1 billion US dollars in 2022. Transactions involving drugs from these leading companies can be filtered by clicking on the "Leading Company" tag on the left-hand side.
In addition to the drug transaction module, you can also view related transaction history on the drug detail page and the institution detail page.
Click on the image below to explore new pharmaceutical funding transactions!
2024-12-11
CHICAGO--(
BUSINESS WIRE
)--Meitheal Pharmaceuticals, Inc. (“Meitheal”), a fully integrated biopharmaceutical company based in Chicago focused on the development and commercialization of generic, fertility, biologic, and branded injectable products, announced it has secured exclusive commercial rights in the U.S. to XENLETA
®
(lefamulin acetate) through an exclusive license and supply agreement with its parent company, Hong Kong King-Friend Industrial Co., Ltd. (HKF). XENLETA
®
belongs to a new class of novel antibiotics and is approved in intravenous and oral formulations in the U.S. and multiple other countries for the treatment of community-acquired bacterial pneumonia (CABP) in adults.
HKF has acquired global rights to XENLETA
®
(with the exception of Greater China) from Nabriva Therapeutics. Through the acquisition, HKF has obtained substantially all global assets related to XENLETA
®
, including results of development and regulatory activities.
“The licensing of XENLETA
®
bolsters our portfolio of novel antibiotics and reflects our focus on addressing the growing issue of antimicrobial resistance,” said Tom Shea, Chief Executive Officer of Meitheal. “As the first approved medicine of an entirely new class of antibiotics, XENLETA
®
is an innovative therapeutic option that will be available to the patients affected by CABP and has been shown to be active against various bacterial strains. We look forward to leveraging our end-to-end expertise in biopharmaceutical development and commercialization to bring this important therapeutic to patients in need.”
XENLETA
®
is a first-in-class semi-synthetic pleuromutilin antibiotic. As a monotherapy offering a complete spectrum of coverage for the main CABP pathogens and with a low propensity for the development of bacterial resistance, XENLETA
®
represents a critical step in addressing the growing global public health crisis of antimicrobial resistance (AMR) and supports the principles of antimicrobial stewardship.
“Antimicrobial resistance, unfortunately, undermines the treatment paradigms of many infectious diseases globally, leading to poor patient outcomes and increased costs to healthcare systems,” said Brett Novak, Meitheal’s Senior Vice President of Commercial Operations. “XENLETA
®
provides a unique and well-tolerated product profile for the more than five million annual cases of CABP in the U.S., where it has the potential to serve as a first-line monotherapy option in both the inpatient and outpatient settings. We are pleased that this agreement will allow us to unlock synergies with our existing franchises and deliver critical medicines that address large gaps in the antibiotic treatment landscape.”
Global approvals of XENLETA
®
in CABP are based on the results of two global, pivotal Phase 3 trials, LEAP 1 and LEAP 2, in which XENLETA
®
met all primary endpoints.
Meitheal recently added the first anti-infective to its portfolio through an exclusive commercialization agreement with HKF—CONTEPO™. Meitheal will leverage its new aligned-to-CONTEPO
™
marketing, sales, and medical science liaison teams to support the launch of XENLETA
®
, which shares similar hospital call points. Meitheal will further establish practice-based support for key prescribers and patients that could benefit from XENLETA
®
.
“We are pleased to have acquired the rights to XENLETA
®
and look forward to supporting Meitheal as it delivers this important medication to patients in the U.S.,” said Eric Tang, President of HKF. “We are committed to supporting Meitheal’s work to deliver accessible, sustainable, and innovative healthcare solutions and we remain focused on continuing to invest in the research, development, and commercialization of branded pharmaceuticals to achieve this goal.”
HKF and its related entities have invested over $300 million in capital and research and development in recent years to support sustainable product supply across key focus areas, including branded biopharmaceuticals. The licensing agreement for XENLETA
®
adds a third branded biopharmaceutical and first on-market branded product to Meitheal’s portfolio.
ABOUT COMMUNITY-ACQUIRED BACTERIAL PNEUMONIA (CABP)
Pneumonia is an infection of the lung that can be serious and fatal, especially among older adult patients with comorbidities. CABP is among the most common types of pneumonia, with five million cases in the U.S. each year.
1
In the U.S., CABP is the leading cause of infection-related death
2
and the fourth leading cause of hospitalization,
3
a setting where mortality rates are approximately 15%
4
. Certain bacteria that cause CABP have become resistant to one common antibiotic, macrolides, at a rate on average of 50%.
5
The U.S. FDA has also issued multiple warnings about the resistance of one current class of CABP treatments called fluoroquinolones.
6
Antimicrobial resistance (AMR) is a top global public health threat that creates challenges treating infections and performing medical procedures and increases the risk of death and disability.
7
Novel antibiotics that kill bacteria, including those that cause CABP, in a different way are essential to addressing AMR.
8
ABOUT XENLETA
®
XENLETA
®
(lefamulin acetate) is a first-in-class, semi-synthetic pleuromutilin antibiotic for systemic administration in humans. It is designed to inhibit the synthesis of bacterial protein, which is required for bacteria to grow. XENLETA
®
’s binding occurs with high affinity, high specificity, and at molecular sites that are different than other antibiotic classes. Two multicenter, multinational, double-blind, double-dummy, non-inferiority trials assessing a total of 1,289 patients with CABP demonstrated XENLETA
®
’s efficacy. In these trials, XENLETA
®
was compared with moxifloxacin, and in one trial, moxifloxacin with and without linezolid. Patients who received XENLETA
®
had similar rates of efficacy as those taking moxifloxacin alone or moxifloxacin plus linezolid.
CONTRAINDICATIONS
XENLETA
®
is contraindicated in patients with known hypersensitivity to lefamulin, pleuromutilin class drugs, or any of the components of XENLETA
®
. Concomitant use of XENLETA
®
tablets with CYP3A substrates that prolong the QT interval is contraindicated.
WARNINGS AND PRECAUTIONS
QT Prolongation: Avoid use in patients with known QT prolongation, ventricular arrhythmias including torsades de pointes, and patients receiving drugs that prolong the QT interval such as antiarrhythmic agents. Embryo-Fetal Toxicity: May cause fetal harm. Advise females of reproductive potential of the potential risk to the fetus and to use effective contraception. Clostridioides difficile-associated Diarrhea: Evaluate patients who develop diarrhea.
ADVERSE REACTIONS
The most common adverse reactions associated with XENLETA
®
Injection include administration site reactions, hepatic enzyme elevation, nausea, hypokalemia, insomnia and headache. The most common adverse reactions associated with XENLETA
®
Tablets include diarrhea, nausea, vomiting, hepatic enzyme elevation.
Please see Full Prescribing Information for more information.
ABOUT MEITHEAL PHARMACEUTICALS, INC.
Founded in 2017 and based in Chicago, Meitheal is focused on the development and commercialization of generic injectable medications and, as of 2022, has expanded its focus to include fertility, biologic, and branded products. Meitheal currently markets over 60 U.S. Food and Drug Administration (FDA)-approved products across numerous therapeutic areas including anti-infectives, oncolytics, intensive care, and fertility. As of October 2024, Meitheal, directly or through its partners, has 18 products in the research and development phase, 6 additional products planned for launch in 2024, and 21 products under review by the FDA. Meitheal’s mission is to provide easy access to fairly-priced products through robust manufacturing, consistent supply, and rapid response to our customers’ needs. Ranked #2 in 2024 on Crain’s Fast 50 in Chicago, and in the top 100 of Crain’s Best Places to Work in Chicago from 2022 to 2024, Meitheal emulates the traditional Irish guiding principle we are named for — working together toward a common goal, for the greater good.
Learn more about who we are and what we do at
www.meithealpharma.com
.
ABOUT HONG KONG KING-FRIEND INDUSTRIAL COMPANY (HKF)
Hong Kong King-Friend Industrial Company is a wholly owned subsidiary of Nanjing King-Friend Biochemical Pharmaceutical Company, founded in 2010.
ABOUT NANJING KING-FRIEND BIOCHEMICAL PHARMACEUTICAL COMPANY (NKF)
Nanjing King-Friend Biochemical Pharmaceutical Co., Ltd. is a China-based company principally engaged in the research and development, production and sales of Active Pharmaceutical Ingredients (API) and Finished Dosage Form (FDF). Established in 1986 as one of the world’s leading manufacturers of heparin-related APIs, NKF has grown into a fully integrated API and FDF manufacturer in multiple therapeutic areas including critical care and oncology. With three U.S. FDA-approved manufacturing sites in China and more than 500 employees, including more than 100 dedicated research and development experts, NKF strives to meet patient needs globally with market presence in the U.S., China, EU and across the world. NKF is publicly listed on the Shanghai Stock Exchange with a market capitalization over U.S. $3.0 billion.
ABOUT NABRIVA THERAPEUTICS PLC
Nabriva Therapeutics is a biopharmaceutical company engaged in the commercialization and development of innovative anti-infective agents to treat serious infections. Nabriva Therapeutics received U.S. FDA approval for XENLETA
®
(lefamulin injection, lefamulin tablets), the first systemic pleuromutilin antibiotic for community-acquired bacterial pneumonia (CABP). Nabriva Therapeutics also previously developed CONTEPO™ (fosfomycin for injection), a potential first-in-class epoxide antibiotic for complicated urinary tract infections (cUTI).
___________________________
1
National Ambulatory Medical Care Survey (NAMCS) and National Hospital Ambulatory Medical Care Survey (NHAMCS) 2009 -2010.
https://archive.cdc.gov/#/details?url=https://www.cdc.gov/nchs/data/ahcd/combined_tables/2009-2010_combined_web_table01.pdf
(Last Accessed December 4, 2024).
2
el Bcheraoui C, Mokdad AH, Dwyer-Lindgren L, et al. Trends and Patterns of Differences in Infectious Disease Mortality Among US Counties, 1980-2014. JAMA.2018;319(12):1248–1260. doi:10.1001/jama.2018.2089.
3
McDermott KW, Roemer M. Most frequent principal diagnoses for inpatient stays in U.S. Hospitals, 2018: Statistical Brief, no 277. In: Healthcare Cost and Utilization Project (HCUP) Statistical Briefs. Rockville, MD: Agency for Healthcare Research and Quality. 2021.
https://hcup-us.ahrq.gov/reports/statbriefs/sb277-Top-Reasons-Hospital-Stays-2018.pdf
.
4
2017 CHARTBOOK STATIC ANALYSES -Trends in mortality rates following admission for acute myocardial infarction, chronic obstructive pulmonary disease, heart failure, pneumonia, and acute ischemic stroke. Prepared for CMS by Yale New Haven Health Services Corporation -Center for Outcomes Research and Evaluation (YNHHSC/CORE) September 2017.
5
Classi P, Landsman-Blumberg P, Carroll C, et al. The relationship between macrolide-resistant streptococcus pneumoniae and treatment failure in adults with community-acquired pneumonia by CDC region in the United States. Abstract J03. In: Meeting abstracts, Academy of Managed Care Pharmacy Nexus 2016; October 3-6, 2016; National Harbor, MD.
6
Food and Drug Administration. FDA updates warnings for fluoroquinolone antibiotics on risks of mental health and low blood sugar adverse reactions.
https://www.fda.gov/news-events/press-announcements/fda-updates-warnings-fluoroquinolone-antibiotics-risks-mental-health-and-low-blood-sugar-adverse
. Accessed December 4, 2024.
7
World Health Organization. Antimicrobial resistance.
https://www.who.int/news-room/fact-sheets/detail/antimicrobial-resistance
. Accessed December 4, 2024.
8
Centers for Disease Control and Prevention. Antibiotic Resistance Threats in the United States, 2013, US Department of Health and Human Services.
临床3期引进/卖出上市批准临床结果
2024-01-15
Bactericidal activity demonstrated in vitro and in vivo against broad range of Gram-negative bacteria, including multidrug-resistant strains
Basilea Pharmaceutica Ltd, Allschwil (SIX: BSLN), a commercial-stage biopharmaceutical company committed to meeting the needs of patients with severe bacterial and fungal infections, announced today that it has entered into an asset purchase agreement with Spexis AG (SIX: SPEX) for a preclinical program of antibiotics from a novel class, targeting Gram-negative bacteria, including multidrug-resistant strains.1
Dr. Laurenz Kellenberger, Chief Scientific Officer of Basilea, said: “The acquired antibiotics are of a novel class, targeting the lipopolysaccharide transport in Gram-negative bacteria, which have been highlighted by the World Health Organization as priority pathogens against which new antibiotics are urgently needed. The convincing potent and rapid bactericidal activity against bacteria such as Escherichia coli or Klebsiella pneumoniae, including multidrug-resistant species, and the activity in infection models, is very encouraging. We are excited by the addition of this new program to our growing pipeline and to continue the development of this targeted antibiotics class, which has the potential to address an unmet medical need in the treatment of severe bacterial infections in the hospital.”
The antibiotics were developed within Spexis’ Outer Membrane Protein Targeting Antibiotics (OMPTA) program and selectively disrupt the lipopolysaccharide transport bridge, an essential structure in Gram-negative bacteria. This results in a loss of the integrity of the outer cell membrane, intracellular accumulation of lipopolysaccharides and killing of the bacteria. Activity has been shown in vitro and in vivo against Enterobacteriaceae such as E. coli and K. pneumoniae, including strains resistant to beta-lactams and colistin, an antibiotic regarded as last-resort therapy. The program was funded in part by CARB-X (Combating Antibiotic-Resistant Bacteria Biopharmaceutical Accelerator).2 This underscores the potential of this novel class of antibiotics. CARB-X is a global non-profit partnership dedicated to supporting early-stage antibacterial research and development, to address the rising threat of drug-resistant bacteria.
Basilea is acquiring all program compounds, know-how and intellectual property and is paying Spexis up to a total of CHF 2 million, which consists of an upfront payment, a payment related to the transfer of the assets to Basilea, and a potential final milestone payment related to the availability of near-term external funding for the further development of the program. In addition, Basilea assumes the rights and obligations of Spexis, including potential low single-digit percentage royalties on sales, under licensing agreements. The transaction is subject to the approval by the Western District Court of the Canton Basel-Landschaft.
Infections by multidrug-resistant Gram-negative bacteria (GNB) are a major challenge for healthcare professionals. Due to an additional outer cell membrane compared to Gram-positive bacteria, it is more difficult for antibiotics to get into the cell. In addition, this outer membrane carries lipopolysaccharides/endotoxins which induce inflammation and play an important amplifying role in the pathogenesis of infections by GNB and are therefore considered an important virulence factor. Moreover, GNB can acquire resistance to several classes of antibiotics such as carbapenems, fluoroquinolones, tetracyclines and earlier-generation cephalosporins, making infections with GNBs particularly difficult to treat. In 2017, the World Health Organization published a list of 12 classes of priority bacterial pathogens that pose the greatest threat to human health, of which nine classes are Gram-negative.3
Basilea is a commercial-stage biopharmaceutical company founded in 2000 and headquartered in Switzerland. We are committed to discovering, developing and commercializing innovative drugs to meet the needs of patients with severe bacterial and fungal infections. We have successfully launched two hospital brands, Cresemba for the treatment of invasive fungal infections and Zevtera for the treatment of bacterial infections. In addition, we have preclinical and clinical anti-infective assets in our portfolio. Basilea is listed on the SIX Swiss Exchange (SIX: BSLN). Please visit basilea.com.
References
M. Schuster, E. Brabet, K. K. Oi et al. Peptidomimetic antibiotics disrupt the lipopolysaccharide transport bridge of drug-resistant Enterobacteriaceae. Science Advances 2023 (9), eadg3683
Research reported in this press release is supported by CARB-X. CARB-X’s funding for this project is provided in part with federal funds from the US Department of Health and Human Services; Administration for Strategic Preparedness and Response; Biomedical Advanced Research and Development Authority; under agreement number 75A50122C00028; and by awards from Wellcome (WT224842) and Germany’s Federal Ministry of Education and Research (BMBF). The content of this press release is solely the responsibility of the authors and does not necessarily represent the official views of CARB-X or any of its funders.
https://www.who.int/news/item/27-02-2017-who-publishes-list-of-bacteria-for-which-new-antibiotics-are-urgently-needed (Accessed: January 14, 2024)
The content above comes from the network. if any infringement, please contact us to modify.
并购
100 项与 AM-1939 相关的药物交易
登录后查看更多信息
研发状态
10 条进展最快的记录, 后查看更多信息
登录
| 适应症 | 最高研发状态 | 国家/地区 | 公司 | 日期 |
|---|---|---|---|---|
| 革兰氏阳性细菌感染 | 药物发现 | 日本 | - |
登录后查看更多信息
临床结果
临床结果
适应症
分期
评价
查看全部结果
| 研究 | 分期 | 人群特征 | 评价人数 | 分组 | 结果 | 评价 | 发布日期 |
|---|
No Data | |||||||
登录后查看更多信息
转化医学
使用我们的转化医学数据加速您的研究。
登录
或

药物交易
使用我们的药物交易数据加速您的研究。
登录
或

核心专利
使用我们的核心专利数据促进您的研究。
登录
或

临床分析
紧跟全球注册中心的最新临床试验。
登录
或

批准
利用最新的监管批准信息加速您的研究。
登录
或

特殊审评
只需点击几下即可了解关键药物信息。
登录
或

生物医药百科问答
全新生物医药AI Agent 覆盖科研全链路,让突破性发现快人一步
立即开始免费试用!
智慧芽新药情报库是智慧芽专为生命科学人士构建的基于AI的创新药情报平台,助您全方位提升您的研发与决策效率。
立即开始数据试用!
智慧芽新药库数据也通过智慧芽数据服务平台,以API或者数据包形式对外开放,助您更加充分利用智慧芽新药情报信息。
生物序列数据库
生物药研发创新
免费使用
化学结构数据库
小分子化药研发创新
免费使用
